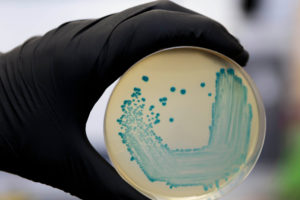
label printing

You are likely to outsource printing your labels to another company. Knowing how important the quality of your label is, you need to be sure that your printer will match the quality you desire for your labels. With so many custom label printers, however, you may not easily know the company to trust with your work. Before settling on a printer, therefore, consider the following points when you want to.
Quality
 This should be your most important consideration. Your printer should be able to produce high-quality labels. If the company uses digital technology, they will probably give you the quality you desire. Digital technology makes it easy for you to create the designs that you need. It also allows you to store your designs and access them faster when you need them. And if you need to change any details on the label, the technology makes it easy to do so.
This should be your most important consideration. Your printer should be able to produce high-quality labels. If the company uses digital technology, they will probably give you the quality you desire. Digital technology makes it easy for you to create the designs that you need. It also allows you to store your designs and access them faster when you need them. And if you need to change any details on the label, the technology makes it easy to do so.
Price
Your printer will be thinking about the cost, quality, and complexity of the design to determine the price to quote for your work. Even with all the factors considered, the price should be realistic. This means that it should provide you the quality and design work that you want and use the materials that will assure you of quality.
Print Management Consistency
The company you will be hiring may have label printing orders from many other companies. As such, they should have a printing management system that allows them to store your artwork safely so that there is no mix up of details. And when you want your order reprinted, they should retrieve your label design fast, print the labels for you, and package your order without mixing it up with other customers’ orders.
Testing
Your printer should be flexible to allow you to try out trendy custom labels to find the one that works best for your product. He or she should also be informed about new labeling techniques and willing to advise you on the label that might suit your product best.
Efficiency
You want to work with a custom label printer that gives you a quick turnaround for your orders. If your labels delay, you might fail to supply your products on time, which may create a stock out of your products. This is not good since you may lose customers to your competitors. A delay may also occur if the printer does not meet your specifications and sends you erroneous labels. Choose a company with a reputation for getting the work done faultlessly and fast.
You want to work with a custom label printer that gives you a quick turnaround for your orders. If your labels delay, you might fail to supply your products on time, which may create a stock out of your products. This is not good since you may lose customers to your competitors. A delay may also occur if the printer does not meet your specifications and sends you erroneous labels. Choose a company with a reputation for getting the work done faultlessly and fast.
Customer Service
This has to do with how your printer treats you. The printer should be effective in communicating, respectful, and responsive to your needs.